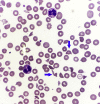

Drug-Induced Thrombotic Microangiopathy Resulting in ESRD
- PMID: 32775839
- PMCID: PMC7403540
- DOI: 10.1016/j.ekir.2020.06.016
Drug-Induced Thrombotic Microangiopathy Resulting in ESRD
Figures

References
Publication types
LinkOut - more resources
Full Text Sources

